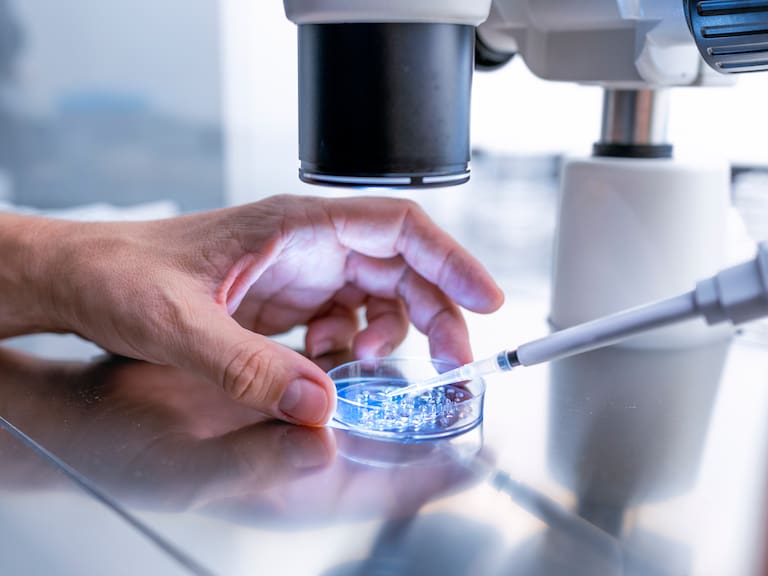
Científicos prueban vacuna universal que promete enfrenta la gripe, COVID y alergias al mismo tiempo

Científicos prueban vacuna universal que promete enfrenta la gripe, COVID y alergias al mismo tiempo
No imita al patógeno. No apunta a un virus concreto. La nueva vacuna desarrollada en Stanford hace algo distinto: habla el idioma del propio sistema inmunitario.
Científicos prueban vacuna universal que promete enfrenta la gripe, COVID y alergias al mismo tiempo / Carlos Duarte
Un equipo de Stanford Medicine (Estados Unidos) probó en ratones una fórmula de vacuna universal que protege contra una amplia gama de virus respiratorios, bacterias e incluso alérgenos.
Esta se administra por vía intranasal, por ejemplo, mediante un aerosol, y proporciona una amplia protección en los pulmones durante varios meses.
En el estudio los investigadores demostraron que los ratones vacunados estaban protegidos contra el SARS-CoV-2 y otros coronavirus, infecciones comunes adquiridas en hospitales, y los ácaros del polvo doméstico (un alérgeno común).
Si se traslada a los humanos, esta vacuna podría sustituir a las múltiples inyecciones anuales contra las infecciones respiratorias estacionales y estar disponible en caso de que surgiera un nuevo virus pandémico, aseguran los investigadores, que publican sus hallazgos en la revista Science.
Una vacuna que no imita al patógeno
La nueva vacuna no se parece a otras, asegura un comunicado de Stanford Medicine. Esta no intenta imitar ninguna parte de un patógeno, sino que emula las señales que las células inmunitarias utilizan para comunicarse entre sí durante una infección. Esta novedosa estrategia integra las dos ramas de la inmunidad –la innata y la adaptativa– creando un bucle de retroalimentación que mantiene una amplia respuesta inmunitaria.
Revisa también:

El sistema inmunitario adaptativo es el motor de las vacunas actuales. Produce agentes especializados, como anticuerpos y células T, que se dirigen a patógenos específicos y los recuerdan durante años.
El innato, que se activa a los pocos minutos de una nueva infección, ha recibido menos atención porque normalmente solo dura unos días antes de ceder el protagonismo al sistema inmunitario adaptativo. El equipo liderado por Bali Pulendran se fijó sobre todo en el innato.
Y es que desde hace tiempo hay indicios de que la inmunidad innata puede durar más tiempo en determinadas circunstancias.
Cómo activa el sistema inmunitario innato
La nueva vacuna, conocida por ahora como GLA-3M-052-LS+OVA, imita las señales de las células T (un tipo de glóbulos blancos) que estimulan directamente las células inmunitarias innatas de los pulmones. También contiene un antígeno inofensivo, una proteína del huevo llamada ovoalbúmina, que recluta células T en los pulmones para mantener la respuesta innata durante semanas o meses.
En los experimentos se administró a los ratones una gota de la vacuna en la nariz y algunos recibieron varias dosis, con una semana de diferencia entre ellas. A continuación, se expuso a cada uno a un tipo de virus respiratorio.
Con tres dosis de la vacuna, estos quedaron protegidos contra el SARS-CoV-2 y otros coronavirus durante al menos tres meses. En los ratones no vacunados, los virus causaron una pérdida de peso drástica, un signo de enfermedad, y a menudo la muerte; sus pulmones estaban inflamados y llenos de virus.
La vacuna supone un “doble golpe”: la respuesta innata prolongada redujo la cantidad de virus en los pulmones en 700 veces y los virus que evadieron esta defensa inicial se encontraron con una rápida respuesta adaptativa en los pulmones.
Los investigadores ampliaron sus pruebas a infecciones respiratorias bacterianas, Staphylococcus aureus y Acinetobacter baumannii. Los ratones vacunados también estuvieron protegidos contra estas durante unos tres meses, señalan las mismas fuentes.
En cuanto a los alérgenos, el equipo expuso a los animales a una proteína de los ácaros del polvo doméstico, un desencadenante común del asma alérgica; los ratones vacunados mantuvieron las vías respiratorias despejadas.
El camino hacia ensayos clínicos en humanos
Los investigadores esperan probar la vacuna en humanos, primero en un ensayo de seguridad de fase I y, si tiene éxito, en uno más amplio.
Pulendran cree que dos dosis de un espray nasal serían suficientes para proporcionar protección en humanos. En el mejor de los casos, con suficiente financiación, estima que una vacuna respiratoria universal podría estar disponible en cinco o siete años.
FEW (EFE, Science, Stanford Medicine)
Sigue a ADN.cl en Google Discover
Recibe nuestros contenidos directamente en tu feed.
























